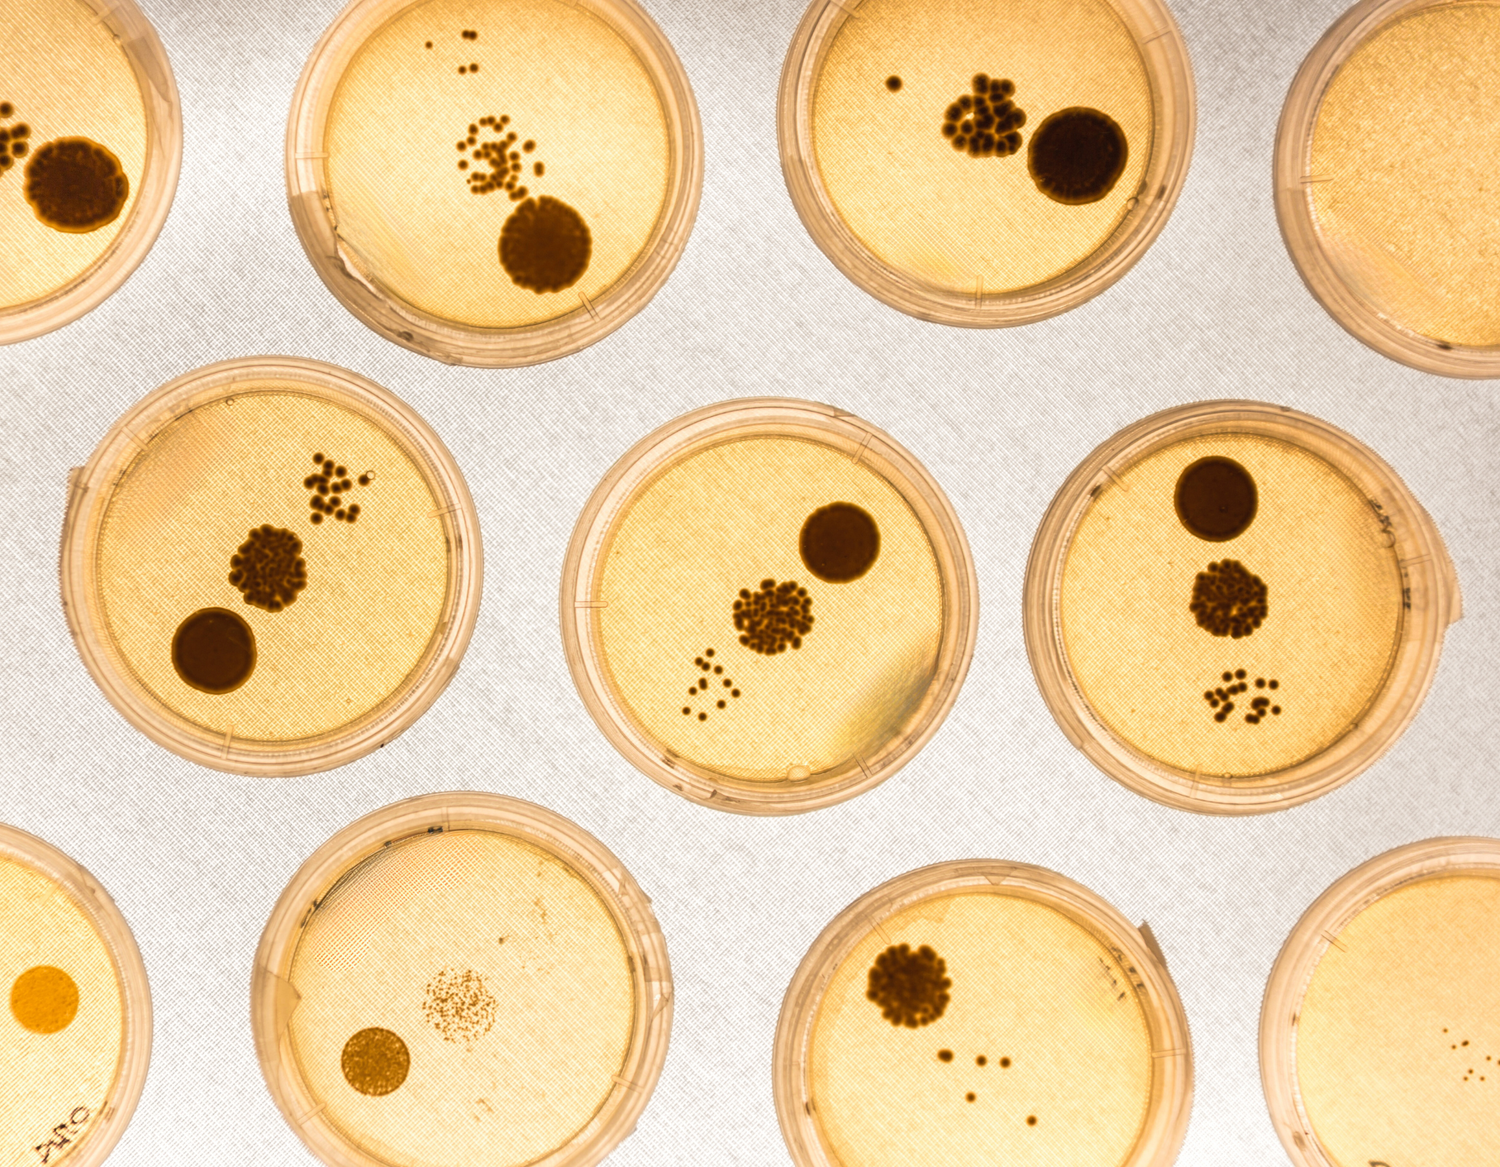

Best Seller
At Teluris, we like good bacteria.
The kind that forms the protective layer called the microbiome, which is the key to clear, healthy, and youthful skin
More than a Microbiome
Prebiotics
Prebiotics work as a fertilizer for good bacteria and balance the skin's microbiome, strengthening its protective barrier and leading to improved hydration and reduced sensitivity.
Probiotics
Live beneficial bacteria that, when applied to the skin, can enhance its health by regulating pH, moisture levels, and strengthening the skin barrier.
Postbiotics
Byproducts of probiotic bacteria that provide benefits, such as reducing inflammation and supporting the skin's immune system.

New Collections

- Regular price
-
$38.00 - Regular price
-
- Sale price
-
$38.00
- Regular price
-
$37.00 - Regular price
-
- Sale price
-
$37.00


- Regular price
-
$38.00 - Regular price
-
- Sale price
-
$38.00


- Regular price
-
$37.00 - Regular price
-
- Sale price
-
$37.00
Discover Our Formulations

SKIN-SAFE FORMULATIONS
Our safe science approach combines cutting-edge microbiome research with clean, non-toxic ingredients to create skincare that is both effective and gentle.

CLEAN INGREDIENTS
The health of your microbiome comes first. Our EWG green only formulas nourish your good bacteria for balanced, glowing skin. We would never pollute your microbiome with harsh chemicals that lead to inflammaging.
In addition to our microbiome boosting formula, our products are packed with a number of ingredients designed to gently revitalize your skin.

- Regular price
-
$37.00 - Regular price
-
- Sale price
-
$37.00
- Regular price
-
$32.00 - Regular price
-
- Sale price
-
$32.00
Add the set and get 20% off.
CLEANSING SET
Follow us
@telurisbeauty